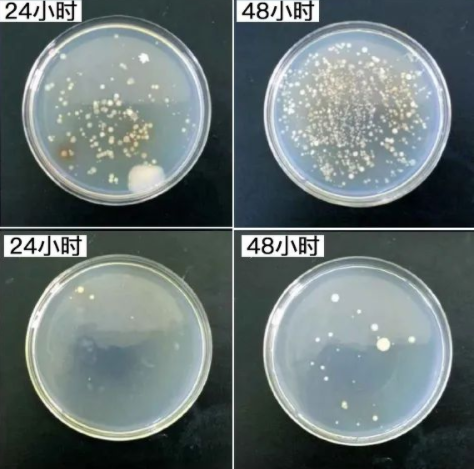

夏天对有脚气的朋友来说堪比上刑
没走多远便容易出汗
鞋子和袜子潮湿到黏在一起
那股酸馊的异味……

随之而来的还有奇痒难耐...
走几步路就恨不得脱掉鞋子挠一挠💥
晚上更是痒得停不下来!严重影响了日常工作和生活

原因就在于足部人体汗腺最发达的部位之一
约25万条汗腺不断分泌汗液
而我们平均每日穿鞋时长却超过12小时
在汗液和足底角蛋白的滋养下
鞋袜表面可能滋生过多种致病真菌!


擦过的擦脚布,穿过的拖鞋和袜子,甚至摸过脚的手
都有可能把脚气传播开去!
除了脚上会传染,手上、身上一样会被传染!
从脚气成为手癣、股癣、金钱癣等等
一旦破溃,还可能引发感染、丹毒!!


为了祛除脚部异味
小编几乎用尽了各种方法,洗!泡!涂药!
然而市面上大部分祛除异味的产品
为了能快速见效都含有激素成分
但脚汗的存在依旧会产生源源不断的真菌
长期使用,还可能会导致皮肤免疫力下降
使得脚部异味反复频率越来越高,造成依赖性

加上气温的升高
真菌繁殖速度也会在高温中更新换代
脚部异味问题会变得越来越严重
想要深度消灭异味,说白了还得抑制真菌才行!
当然光抑制真菌也不够,还会导致复发!
想真正改善问题,靠的不是单一的止痒,而是科学调节
正确的方式是抑菌+修护,不给真菌复发空间
脚部异味自然能有效改善!

来自美国原装进口的Breathy侧柏叶抗菌肽脚气喷雾
天然抑菌植物+抗菌肽科技抗菌
科学精细成分配比
常年被脚气困扰还是大汗脚的小编亲测有效
用了一瓶,脚部瘙痒、异味水泡已经完全消失

点击下方立即购买👇
官方实验测试表明
它对各种菌群的的抑制率❗高达99.9%
远高于国家标准的90%!一喷即抑菌

真人实测报告
使用7天内显著改善脚趾间瘙痒、脚底粗糙、出汗异味
14天缓解脱皮现象
21天瘙痒、脱皮、异味几乎被完全治愈

由于成分温和,效果显著,它也成为了欧美的“脚卫士”
也因此一上市就拿奖到手软
在全美乃至全球都得到了推荐
是美国足部健康协会的御用产品


脚气杀手非它莫属,国内外用过的都在夸!
运动员@John:夏天因为运动出脚汗特别多,严重影响了他的日常生活
在使用布雷辛脚气喷雾后,脚部异味明显减轻了,瘙痒也得到了缓解,溃疡处也好多了!

25岁的林小姐:之前发现脚趾缝陆陆续续发痒、出现小水泡,后来就开始脱皮




Breathy侧柏叶抗菌肽喷雾

现在品牌特价回馈
美国【原装进口】Breathy侧柏叶抗菌肽喷雾
限时折扣价:49元/瓶;79/2瓶

点击下方立即购买👇



你是不是还在每晚用碘伏、醋泡脚?
早就辟谣了!单独用食醋、碘伏泡脚,不可能从根本上治好脚气
想要从根本上抑制真菌还要从源头抓起
布雷辛特别选用北美原产的侧柏叶提取物
侧柏叶中含有黄酮类化合物和挥发油等成分
这些成分能够抑制脚部马拉色菌等真菌的生长繁殖

另加入从澳大利亚蓝桉树、布里斯班蓝蒲公英、昆士兰黄金贝壳粉中
提取的专利抗菌肽——医学界公认的细菌清道夫
靶向杀菌,避免耐药性,长效防护


辅以布雷辛的医学专家创新的活化提炼技术
更让灭菌效果、抑菌时长
相比传统的足部喷雾,足足约提高6倍之久!
从下面对照组可以看到,喷了抑菌喷雾的培养皿已经被消灭了99%
而没有喷布雷辛脚气喷雾的已经被细菌占领...

配合新型靶向导入技术能快速渗透肌肤,中和异味分子
快速抑菌、同时舒缓不适,修复肌肤屏障
不仅能在短时间消除异味
还能从源头抵御皮下汗腺,减少足部的出汗量、杜绝异味




有多少朋友是因为药膏的黏腻、脏手而无法坚持打退堂鼓
涂抹费事不说,稍不注意还蹭的床单被子哪里都是...

布雷辛创新用植物精油与月见草脂质结合,轻膜包裹有效成分
喷上即成膜,干爽不黏脚,持效不打折

从香茅草里提取拥有天然抗菌特性的香茅油
能有效抑制细菌的滋生,从而减少异味的产生

桉叶油对化脓性细菌、金黄色葡萄球菌具有较强的抑制作用
清新除味,祛除汗臭,抑菌更安心,清爽穿鞋无负担





库拉索芦荟:抑菌届的天然大佬
里面的芦荟素、氨基酸、甾醇类化合物等,都对抑制菌群有很好的效果

“肌肤韧性剂”胶原蛋白
与人类肌肤亲和度极高,能让萎缩的胶原蛋白重现活性,从而提高皮肤韧性弹性!
月见草油富含高活性γ-亚麻酸,修护干裂角质,缓解紧绷不适

水杨酸+蛋白酶温和促进角质代谢
清除菌源藏匿处,加速废旧角质脱落
协同修复干裂与不适,重建脚部肌肤屏障



产品质量更是经过权威认证



清洁并擦干脚部后,距离5-10cm均匀喷洒于脚底、趾缝等易出汗部位
无需冲洗,自然风干即可
出汗多或运动后可增加使用频次
每日喷2次,快速吸收!
清新草本气味,延长净味时效

质地像清水一样润
并且喷出来的水雾很细腻💦
能够全面均匀的覆盖在脚上,
清爽不黏腻,即喷即干
“香港脚“的重度臭味,用它也能轻松除掉

出门换鞋前喷一喷,双脚清新一整天
运动后、洗脚后喷一喷,祛除异味杀菌止痒
旅行途中喷一喷,放松双脚出行更轻松

现在品牌特价回馈
美国【原装进口】Breathy侧柏叶抗菌肽喷雾
限时折扣价:49元/瓶;79/2瓶

